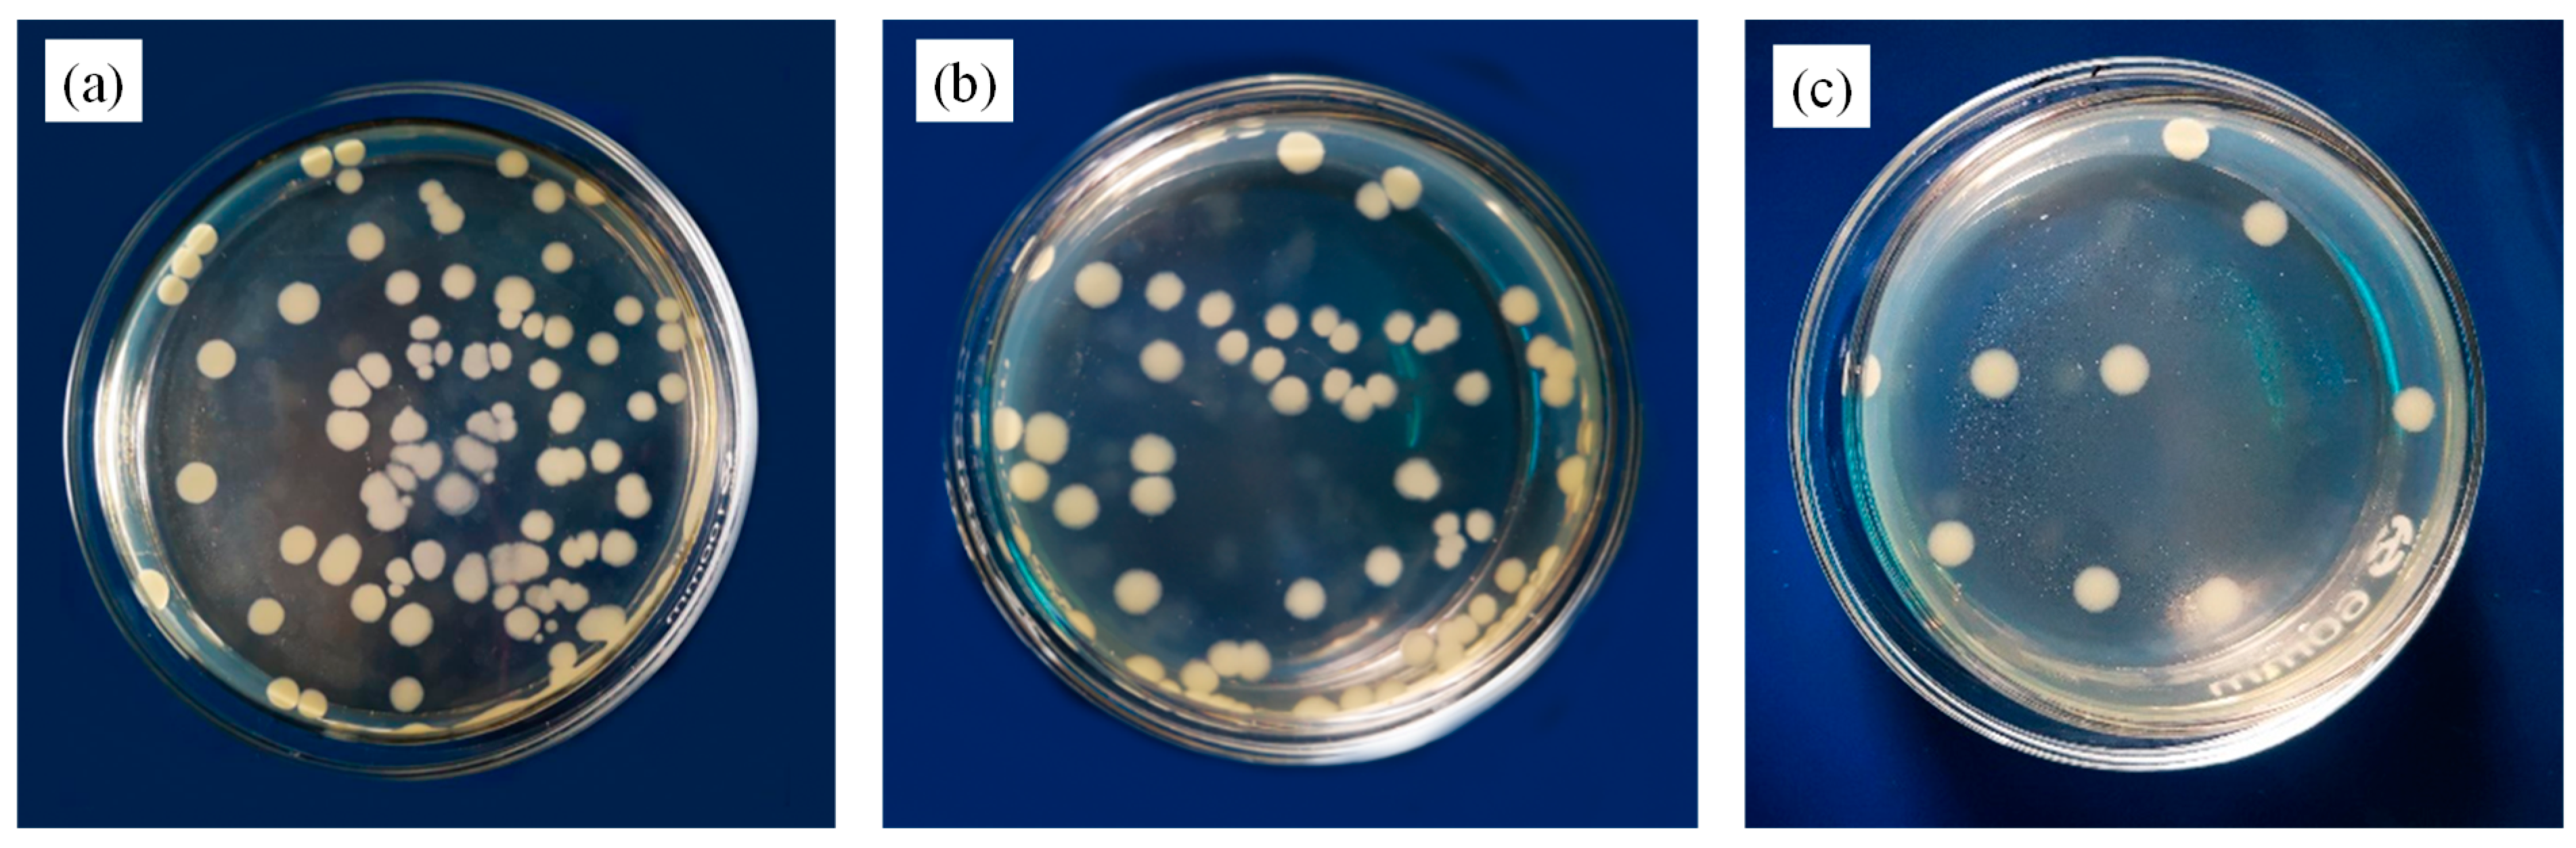
Polymers 12 00621 g013 Polymers 12 00621 g013

Micrometer Copper-Zinc Alloy Particles-Reinforced Wood Plastic Composites with High Gloss and Antibacterial Properties for 3D Printing
Abstract
1. Introduction
2. Experiment
2.1. Materials
2.2. Samples Preparation
2.2.1. Particleboard Wood Flour (PWF) Processing and Chemical Modification
2.2.2. Preparation of micrometer copper-zinc alloy particles-reinforced wood plastic (mCu-Zn/PWF/PLA) composites
2.2.3. Preparation of Filaments and Printing Parameters for FDM 3D Printer
2.3. Characterization
2.3.1. Mechanical Properties
2.3.2. Dynamic Mechanical Thermal Analysis (DMA)
2.3.3. Thermal Gravity Analysis (TGA)
2.3.4. Differential Scanning Calorimetry (DSC)
2.3.5. X-Ray Diffraction (XRD)
2.3.6. Scanning Electron Microscopy (SEM) and Energy Dispersive Spectrometer (EDS)
2.3.7. Surface Gloss Analysis
2.3.8. Antibacterial Testing
3. Results and Discussion
3.1. FTIR Results
3.2. Elemental Analysis
3.3. Mechanical Properties
3.4. Dynamic Mechanical Properties
3.5. Thermogravimetry Analysis
3.6. Differential Scanning Calorimetry Analysis
3.7. X-Ray Diffraction Spectrum Analysis
3.8. Morphology of the Composites
3.9. Surface Gloss Analysis
3.10. Antibacterial Activity
3.11. Application in 3D Printing
4. Conclusions
Author Contributions
Funding
Conflicts of Interest
References
- Chrissafis, K.; Antoniadis, G.; Paraskevopoulos, K.M.; Vassiliou, A.; Bikiaris, D.N. Comparative study of the effect of different nanoparticles on the mechanical properties and thermal degradation mechanism of in situ prepared poly (ε-caprolactone) nanocomposites. Compos. Sci. Technol. 2007, 67, 2165–2174. [Google Scholar] [CrossRef]
- Petchwattana, N.; Covavisaruch, S. Mechanical and morphological properties of wood plastic biocomposites prepared from toughened poly (lactic acid) and rubber wood sawdust (Hevea brasiliensis). J. Bionic. Eng. 2004, 11, 630–637. [Google Scholar] [CrossRef]
- Xu, K.; Li, K.; Tu, D.; Zhong, T.; Xie, C. Reinforcement on the Mechanical-, Thermal-, and Water-Resistance Properties of the Wood Flour/Chitosan/Poly(vinyl chloride) Composites by Physical and Chemical Modification. J. Appl. Polym. Sci. 2014, 131, 40757–40764. [Google Scholar] [CrossRef]
- Daver, F.; Lee, K.P.M.; Brandt, M.; Shanks, R. Cork–PLA composites filaments for fused deposition modelling. Compos. Sci. Technol. 2018, 168, 230–237. [Google Scholar] [CrossRef]
- Balart, J.F.; Garcia-Sanoguera, D.; Balart, R.; Boronat, T.; Sanchez-Nacher, L. Sanchez-Nacher, Manufacturing and properties of biobased thermoplastic composites from poly (lactid acid) and hazelnut shell wastes. Polym. Compos. 2008, 39, 848–857. [Google Scholar] [CrossRef]
- Pringle, A.M.; Rudnicki, M.; Pearce, J.M. Wood Furniture Waste-Based Recycled 3-D Printing Filament. For. Prod. J. 2018, 68, 86–95. [Google Scholar] [CrossRef]
- Que, Z.L.; Furuno, T.; Katoh, S.; Nishino, Y. Evaluation of three test methods in determination of formaldehyde emission from particleboard bonded with different mole ratio in the urea-formaldehyde resin. Build. Environ. 2007, 42, 1242–1249. [Google Scholar] [CrossRef]
- Zhang, L.; Hu, Y.C. Novel lignocellulosic hybrid particleboard composites made from rice straws and coir fibers. Mater. Des. 2014, 55, 19–26. [Google Scholar] [CrossRef]
- Chaharmahali, M.; Tajvidi, M.; Najafi, S.K. Mechanical properties of wood plastic composites panels made from waste fiberboard and particleboard. Polym. Compos. 2008, 29, 606–610. [Google Scholar] [CrossRef]
- Saini, R.K.; Bagri, L.P.; Bajpai, A.K. Nano-silver hydroxyapatite based antibacterial 3D scaffolds of gelatin/alginate/poly (vinyl alcohol) for bone tissue engineering applications. Colloid. Surf. B. 2019, 177, 211–218. [Google Scholar] [CrossRef]
- Fortunati, E.; Armentano, I.; Zhou, Q.; Iannoni, A.; Saino, E.; Visai, L.; Berglund, L.A.; Kenny, J.M. Multifunctional bionanocomposites films of poly (lactic acid), cellulose nanocrystals and silver nanoparticles. Carbohyd. Polym. 2012, 87, 1596–1605. [Google Scholar] [CrossRef]
- Tripathi, A.; Saravanan, S.; Pattnaik, S.; Moorthi, A.; Partridge, N.C.; Selvamurugan, N. Bio-composites scaffolds containing chitosan/nano-hydroxyapatite/nano-copper-zinc for bone tissue engineering. Int. J. Biol. Macromol. 2012, 50, 294–299. [Google Scholar] [CrossRef] [PubMed]
- Rodriguez-Tobias, H.; Morales, G.; Grande, D. Comprehensive review on electrospinning techniques as versatile approaches toward antimicrobial biopolymeric composites fibers. Mat. Sci. Eng. C-Mater. 2019, 101, 306–322. [Google Scholar] [CrossRef] [PubMed]
- Alaimo, G.; Marconi, S.; Costato, L.; Auricchio, F. Influence of meso-structure and chemical composition on FDM 3D-printed parts. Compos. Part. B-Eng. 2017, 113, 371–380. [Google Scholar] [CrossRef]
- Weng, Z.; Wang, J.; Senthil, T.; Wu, L. Mechanical and thermal properties of ABS/montmorillonite nanocomposites for fused deposition modeling 3D printing. Mater. Des. 2016, 102, 276–283. [Google Scholar] [CrossRef]
- Tian, X.Y.; Liu, T.F.; Yang, C.C.; Wang, Q.R.; Li, D.C. Interface and performance of 3D printed continuous carbon fiber reinforced PLA composites. Compos. Part. a-Appl. S. Manuf. 2016, 88, 198–205. [Google Scholar] [CrossRef]
- Le Duigou, A.; Castro, M.; Bevan, R.; Martin, N. 3D printing of wood fibre biocomposites: From mechanical to actuation functionality. Mater. Des. 2016, 96, 106–114. [Google Scholar] [CrossRef]
- Mazzanti, V.; Malagutti, L.; Mollica, F. FDM 3D printing of polymers containing natural Fillers: A review of their mechanical properties. Polymers 2019, 11, 1094. [Google Scholar] [CrossRef]
- Nam, J.Y.; Ray, S.S.; Okamoto, M. Crystallization behavior and morphology of biodegradable polylactide/layered silicate nanocomposites. Macromolecules 2003, 36, 7126–7131. [Google Scholar] [CrossRef]
- Rocha, R.S.; Oliveira, A.C.; Caneppele, T.M.F.; Bresciani, E. Effect of Artificial Aging Protocols on Surface Gloss of Resin Composites. Int. J. Dent. 2017, 2017, 3483171. [Google Scholar] [CrossRef]
- Anagnostou, M.; Chelioti, G.; Chioti, S.; Kakaboura, A. Effect of tooth-bleaching methods on gloss and color of resin composites. J. Dent. 2010, 38, E129–E136. [Google Scholar] [CrossRef] [PubMed]
- Hosoya, Y.; Shiraishi, T.; Puppin-Rontani, R.M.; Powers, J.M. Effects of acidulated phosphate fluoride gel application on surface roughness, gloss and colour of different type resin composites. J. Dent. 2011, 39, 700–706. [Google Scholar] [CrossRef] [PubMed]
- Lefever, D.; Perakis, N.; Roig, M.; Krejci, I.; Ardu, S. The effect of toothbrushing on surface gloss of resin composites. Am. J. Dent. 2012, 25, 54–58. [Google Scholar] [PubMed]
- Marra, A.; Silvestre, C.; Duraccio, D.; Cimmino, S. Polylactic acid/zinc oxide biocomposite films for food packaging application. Int. J. Biol. Macromol. 2016, 88, 254–262. [Google Scholar] [CrossRef] [PubMed]
- Wang, F.F.; Sun, Z.Y.; Yin, J.; Xu, L. Preparation, Characterization and Properties of Porous PLA/PEG/Curcumin Composites Nanofibers for Antibacterial Application. Nanomaterials-Basel 2019, 9, 508. [Google Scholar] [CrossRef]
- Reddy, K.O.; Guduri, B.R.; Rajulu, A.V. Structural Characterization and Tensile Properties of Borassus Fruit Fibers. J. Appl. Polym. Sci. 2009, 114, 603–611. [Google Scholar] [CrossRef]
- Liu, C.F.; Xu, F.; Sun, J.X.; Ren, J.L.; Curling, S.; Sun, R.C.; Fowler, P.; Baird, M.S. Physicochemical characterization of cellulose from perennial ryegrass leaves (Lolium perenne). Carbohyd. Res. 2006, 341, 2677–2687. [Google Scholar] [CrossRef]
- Reddy, K.O.; Reddy, K.R.N.; Zhang, J.; Zhang, J.M.; Rajulu, A.V. Effect of Alkali Treatment on the Properties of Century Fiber. J. Nat. Fibers. 2013, 10, 282–296. [Google Scholar] [CrossRef]
- Lv, S.S.; Gu, J.Y.; Tan, H.Y.; Zhang, Y.H. The morphology, rheological, and mechanical properties of wood flour/starch/poly(lactic acid) blends. J. Appl. Polym. Sci. 2017, 134, 44743–44752. [Google Scholar] [CrossRef]
- Tao, Y.B.; Wang, H.L.; Li, Z.L.; Li, P.; Shi, S.Q. Development and Application of Wood Flour-Filled Polylactic Acid Composite Filament for 3D Printing. Materials 2017, 10, 339. [Google Scholar] [CrossRef]
- Wang, C.; Smith, L.M.; Zhang, W.; Li, M.; Wang, G.; Shi, S.Q.; Cheng, H.; Zhang, S. Reinforcement of Polylactic Acid for Fused Deposition Modeling Process with Nano Particles Treated Bamboo Powder. Polymers 2019, 11, 1146. [Google Scholar] [CrossRef] [PubMed]
- Yang, Y.X.; Haurie, L.; Wen, J.H.; Zhang, S.D.; Ollivier, A.; Wang, D.Y. Effect of oxidized wood flour as functional filler on the mechanical, thermal and flame-retardant properties of polylactide biocomposites. Ind. Crop. Prod. 2019, 130, 301–309. [Google Scholar] [CrossRef]
- Feng, Y.C.; Liang, H.Y.; Yang, Z.M.; Yuan, T.; Luo, Y.; Li, P.W.; Yang, Z.H.; Zhang, C.Q. A Solvent-Free and Scalable Method To Prepare Soybean-Oil-Based Polyols by Thiol-Ene Photo-Click Reaction and Biobased Polyurethanes Therefrom. Acs. Sustain. Chem. Eng. 2017, 5, 7365–7373. [Google Scholar] [CrossRef]
- Islam, M.S.; Hamdan, S.; Talib, Z.A.; Ahmed, A.S.; Rahman, M.R. Tropical wood polymer nanocomposites (WPNC): The impact of nanoclay on dynamic mechanical thermal properties. Compos. Sci. Technol. 2012, 72, 1995–2001. [Google Scholar] [CrossRef]
- Deka, B.K.; Maji, T.K.; Mandal, M. Study on properties of nanocomposites based on HDPE, LDPE, PP, PVC, wood and clay. Polym. Bull. 2011, 67, 1875–1892. [Google Scholar] [CrossRef]
- Venkatesh, G.S.; Deb, A.; Karmarkar, A.; Chauhan, S.S. Effect of nanoclay content and compatibilizer on viscoelastic properties of montmorillonite/polypropylene nanocomposites. Mater. Des. 2012, 37, 285–291. [Google Scholar] [CrossRef]
- Xia, Y.; Zhang, Z.Y.; Kessler, M.R.; Brehm-Stecher, B.; Larock, R.C. Antibacterial Soybean-Oil-Based Cationic Polyurethane Coatings Prepared from Different Amino Polyols. ChemSusChem 2012, 5, 2221–2227. [Google Scholar] [CrossRef]
- Kim, H.S.; Park, B.H.; Choi, J.H.; Yoon, J.S. Mechanical properties and thermal stability of poly(L-lactide)/calcium carbonate composites. J. Appl. Polym. Sci. 2008, 109, 3087–3092. [Google Scholar] [CrossRef]
- Chun, K.S.; Husseinsyah, S.; Osman, H. Properties of coconut shell powder-filled polylactic acid ecocomposites: Effect of maleic acid. Polym. Eng. Sci. 2013, 53, 1109–1116. [Google Scholar] [CrossRef]
- Zhao, Y.Q.; Lau, K.T.; Kim, J.K.; Xu, C.L.; Zhao, D.D.; Li, H.L. Nanodiamond/poly (lactic acid) nanocomposites: Effect of nanodiamond on structure and properties of poly (lactic acid). Compos. Part. B-Eng. 2010, 41, 646–653. [Google Scholar] [CrossRef]
- Kang, K.S.; Lee, S.I.; Lee, T.J.; Narayan, R.; Shin, B.Y. Effect of biobased and biodegradable nucleating agent on the isothermal crystallization of poly (lactic acid). Korean J. Chem. Eng. 2008, 25, 599–608. [Google Scholar] [CrossRef]
- Cheung, H.Y.; Lau, K.T.; Tao, X.M.; Hui, D. A potential material for tissue engineering: Silkworm silk/PLA biocomposites. Compos. Part. B-Eng. 2008, 39, 1026–1033. [Google Scholar] [CrossRef]
- Qian, Y.; Yao, Z.J.; Lin, H.Y.; Zhou, J.T. Mechanical and microwave absorption properties of 3D-printed Li0.44Zn0.2Fe2.36O4/polylactic acid composites using fused deposition modeling. J. Mater. Sci-Mater. El. 2018, 29, 19296–19307. [Google Scholar] [CrossRef]
- Sang, L.; Han, S.; Li, Z.; Yang, X.; Hou, W. Development of short basalt fiber reinforced polylactide composites and their feasible evaluation for 3D printing applications. Compos. Part. B-Eng. 2019, 164, 629–639. [Google Scholar] [CrossRef]
- Long, H.B.; Wu, Z.Q.; Dong, Q.Q.; Shen, Y.T.; Zhou, W.Y.; Luo, Y.; Zhang, C.Q.; Dong, X.M. Mechanical and thermal properties of bamboo fiber reinforced polypropylene/polylactic acid composites for 3D printing. Polym. Eng. Sci. 2019, 59, E247–E260. [Google Scholar] [CrossRef]

| Sample | PWF (%) | mCu-Zn (%) | PLA (%) |
|---|---|---|---|
| PLA-1PWF | 1 | — | 99 |
| PLA-3PWF | 3 | — | 97 |
| PLA-5PWF | 5 | — | 95 |
| PLA-7PWF | 7 | — | 93 |
| PLA-1mCu-Zn | 4.95 | 1 | 94.05 |
| PLA-2mCu-Zn | 4.9 | 2 | 93.1 |
| PLA-3mCu-Zn | 4.85 | 3 | 92.15 |
| PLA-4mCu-Zn | 4.8 | 4 | 91.2 |
| Sample | Tensile Strength (MPa) | Elongation at Break (%) | Flexural Strength (MPa) | Young’s Modulus (GPa) |
|---|---|---|---|---|
| Pure PLA | 43.79 ± 0.84 | 7.00 ± 0.41 | 65.21 ± 0.84 | 0.76 ± 0.20 |
| PLA-1PWF | 45.07 ± 0.55 | 7.41 ± 0.30 | 68.50 ± 0.79 | 1.18 ± 0.11 |
| PLA-3PWF | 47.02 ± 1.02 | 7.73 ± 0.40 | 73.31 ± 0.44 | 2.11 ± 0.25 |
| PLA-5PWF | 52.54 ± 0.69 | 8.52 ± 0.49 | 80.66 ± 1.00 | 3.34 ± 0.17 |
| PLA-7PWF | 45.05 ± 0.67 | 6.45 ± 0.37 | 74.04 ± 0.70 | 3.65 ± 0.18 |
| PLA-1mCu-Zn | 54.55 ± 0.60 | 8.04 ± 0.26 | 92.42 ± 1.17 | 1.70 ± 0.22 |
| PLA-2mCu-Zn | 56.64 ± 0.22 | 8.03 ± 0.40 | 95.92 ± 1.28 | 2.24 ± 0.24 |
| PLA-3mCu-Zn | 54.17 ± 0.37 | 7.83 ± 0.32 | 87.22 ± 1.13 | 2.41 ± 0.11 |
| PLA-4mCu-Zn | 49.30 ± 0.38 | 7.43 ± 0.38 | 85.57 ± 1.13 | 1.47 ± 0.28 |
| Sample | DMA | TGA | ||||
|---|---|---|---|---|---|---|
| Ttan (°C) | E’ at 35 °C (MPa) | Ton (°C) | Tmax (°C) | Tend (°C) | ||
| Pure PLA | 56.6 | 2128.35 | 334.9 | 358.6 | 370.1 | |
| PLA-1PWF | 57.5 | 2248.84 | 316.6 | 345.8 | 358.3 | |
| PLA-3PWF | 58.0 | 1951.70 | 314.3 | 343.7 | 355.3 | |
| PLA-5PWF | 55.7 | 1896.91 | 312.0 | 341.8 | 354.1 | |
| PLA-7PWF | 56.2 | 1555.63 | 309.7 | 337.2 | 348.7 | |
| PLA-1mCu-Zn | 58.9 | 2124.88 | 325.4 | 354.1 | 367.1 | |
| PLA-2mCu-Zn | 58.1 | 2027.33 | 319.5 | 348.9 | 361.7 | |
| PLA-3mCu-Zn | 56.8 | 1813.43 | 330.0 | 356.2 | 367.6 | |
| PLA-4mCu-Zn | 57.1 | 1741.23 | 335.6 | 360.7 | 371.4 | |
| Sample | Glass Transition Temperature Tg (°C) | Crystallization Temperature Tcc (°C) | Melting Temperature Tm (°C) | Melting Enthalpy ΔHm (J/g) | Crystallinity XC (%) |
|---|---|---|---|---|---|
| Pure-PLA | 62.71 | 105.41 | 167.92 | 30.11 | 32.1 |
| PLA-1PWF | 62.45 | 102.15 | 167.32 | 36.31 | 38.8 |
| PLA-3PWF | 62.51 | 106.92 | 167.83 | 31.78 | 33.9 |
| PLA-5PWF | 62.40 | 105.72 | 167.82 | 33.30 | 36.1 |
| PLA-7PWF | 62.31 | 102.32 | 167.36 | 37.51 | 40.0 |
| PLA-1mCu-Zn | 62.45 | 105.80 | 167.95 | 35.77 | 38.2 |
| PLA-2mCu-Zn | 62.51 | 105.93 | 168.17 | 31.81 | 33.9 |
| PLA-3mCu-Zn | 62.57 | 106.80 | 168.10 | 33.41 | 35.7 |
| PLA-4mCu-Zn | 62.67 | 106.08 | 167.09 | 32.71 | 34.9 |
© 2020 by the authors. Licensee MDPI, Basel, Switzerland. This article is an open access article distributed under the terms and conditions of the Creative Commons Attribution (CC BY) license (http://creativecommons.org/licenses/by/4.0/).
Share and Cite
Yang, F.; Zeng, J.; Long, H.; Xiao, J.; Luo, Y.; Gu, J.; Zhou, W.; Wei, Y.; Dong, X. Micrometer Copper-Zinc Alloy Particles-Reinforced Wood Plastic Composites with High Gloss and Antibacterial Properties for 3D Printing. Polymers 2020, 12, 621. https://doi.org/10.3390/polym12030621
Yang F, Zeng J, Long H, Xiao J, Luo Y, Gu J, Zhou W, Wei Y, Dong X. Micrometer Copper-Zinc Alloy Particles-Reinforced Wood Plastic Composites with High Gloss and Antibacterial Properties for 3D Printing. Polymers. 2020; 12(3):621. https://doi.org/10.3390/polym12030621
Chicago/Turabian StyleYang, Feiwen, Jianhui Zeng, Haibo Long, Jialin Xiao, Ying Luo, Jin Gu, Wuyi Zhou, Yen Wei, and Xianming Dong. 2020. "Micrometer Copper-Zinc Alloy Particles-Reinforced Wood Plastic Composites with High Gloss and Antibacterial Properties for 3D Printing" Polymers 12, no. 3: 621. https://doi.org/10.3390/polym12030621
APA StyleYang, F., Zeng, J., Long, H., Xiao, J., Luo, Y., Gu, J., Zhou, W., Wei, Y., & Dong, X. (2020). Micrometer Copper-Zinc Alloy Particles-Reinforced Wood Plastic Composites with High Gloss and Antibacterial Properties for 3D Printing. Polymers, 12(3), 621. https://doi.org/10.3390/polym12030621
